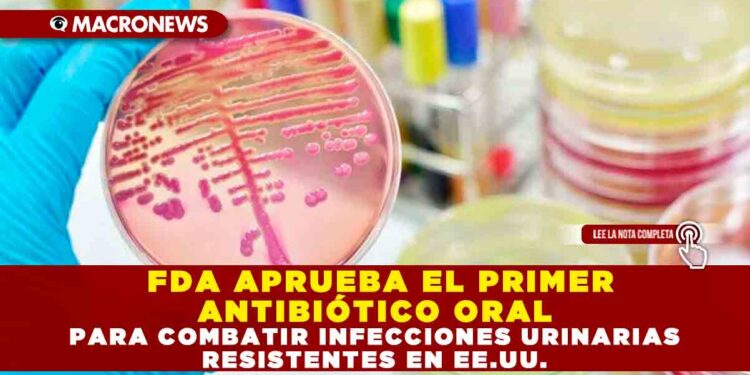
FDA APRUEBA EL PRIMER ANTIBIÓTICO ORAL PARA COMBATIR INFECCIONES URINARIAS RESISTENTES EN EE.UU.

Nuevo antibiótico para infecciones urinarias que persisten

Ahora hay un nuevo tipo de antibiótico para algunas de las infecciones más molestas que existen. Este mes la FDA aprobó Orlynvah, de Iterum Therapeutics, para determinados tipos de infecciones del tracto urinario que no responden a otras drogas.
Las infecciones del tracto urinario se cuentan entre las más comunes, particularmente en mujeres. Si bien antes estas infecciones se trataban con facilidad utilizando antibióticos, hoy hay muchas infecciones resistentes a al menos una o más drogas de las que se utilizaron siempre. Eso implica que no solo cuesta más tratar las infecciones urinarias antes de que causen problemas más serios, sino que aumenta el riesgo de sufrir infecciones urinarias recurrentes. Los científicos han buscado con desesperación antibióticos más nuevos para tratar estas infecciones resistentes.
Orlynvah contiene una combinación de sulopenem etzadroxil, que pertenece a una subclase de antibacterianos llamados penémicos, y probenecid, un inhibidor que se utilizaba para mejorar la duración de los antibióticos en el organismo. Los penémicos son antibióticos sintéticos que muestran gran promesa para el tratamiento de una amplia variedad de gérmenes comúnmente resistentes, pero Orlynvah es el primer penémico oral que se aprueba en EE.UU.

Infecciones resistentes
La droga se aprobó para el tratamiento de infecciones urinarias sin complicaciones causadas por bacterias como Escherichia coli, Klebsiella pneumoniae, o Proteus mirabilis. Es importante destacar que Orlynvah es para personas que no tienen opciones orales antibacterianas alternativas, o cuyas opciones son limitadas para tratar infecciones urinarias, como las que no han respondido a tratamientos anteriores o muestran clara resistencia a otras drogas según lo reflejan los análisis. La FDA aprobó Orlynvah sobre la base de dos ensayos en fase III, que hallaron que era superior o igual en efectividad a otros antibióticos estándar para las infecciones urinarias sin complicaciones, incluyendo las infecciones resistentes.
“La aprobación del sulopenem por parte de la FDA es una gran noticia para los que hemos estado esperando una nueva opción para el tratamiento de pacientes en riesgo que sufren de infecciones urinarias” dijo en una declaración de Iterum Marjorie Golden, especialista en enfermedades infecciosas en el Campus St. Raphael del Hospital Yale New Haven, y que tuvo que ver en la investigación clínica de la droga.
Aunque Orlynvah será algo valioso para médicos y pacientes, no se trata de una droga “curalotodo” para las infecciones urinarias en general. La droga no pasó los ensayos clínicos que testeaban su efectividad contra infecciones urinarias con complicaciones, o infecciones intra-abdominales con complicaciones. Y al igual que todas las drogas antibacterianas nuevas, se administrará con cautela su uso para demorar el surgimiento de cepas de bacterias que desarrollen resistencia contra esta droga.
FUENTE: GIZMODO